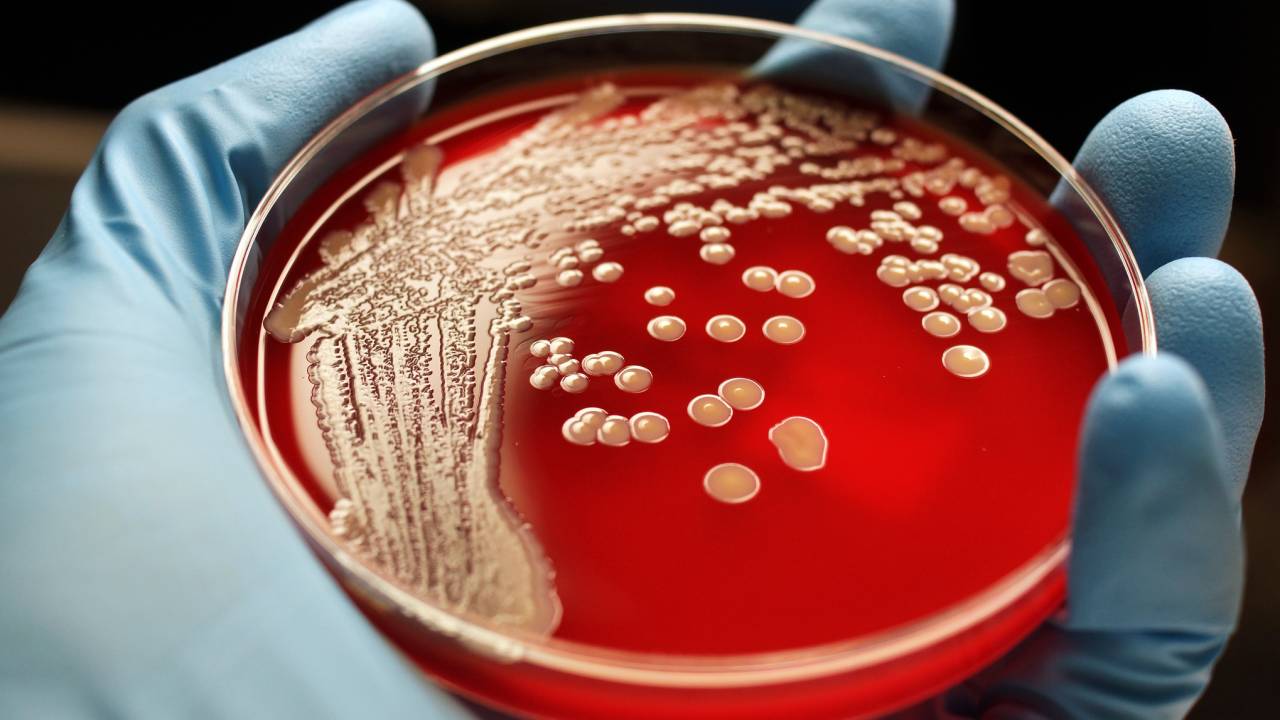

#сибирская язва

В Северный Казахстан вернулась сибирская язва
- 3 Сентября 2021
- 636

Без объявления волны
- 17 Июля 2021
- 51

О вспышке сибирской язвы сообщили в селе Костанайской области
- 13 Июля 2021
- 71

Женщина переехала в дом "в экологически чистом районе": рядом могильник с сибирской язвой
- 12 Мая 2021
- 804

В Алматинской области от сибирской язвы гибнет домашний скот
- 26 Января 2021
- 80
В Шымкенте у двух людей обнаружили сибирскую язву
- 22 Сентября 2020
- 60

В Жамбылской области обнаружили сибирскую язву
- 17 Сентября 2019
- 64

Сибирская язва: кто на новенького
- 5 Сентября 2019
- 1010

Карантин по сибирской язве сняли в Акмолинской области
- 4 Сентября 2019
- 30

Бесбармак спасет мир: как казахская национальная еда борется с сибирской язвой
- 23 Августа 2019
- 2375

Пять человек госпитализированы в Акмолинской области из-за сибирской язвы
- 19 Августа 2019
- 102

Почему дорожает мясо в Казахстане: расследование "КАРАВАНА"
- 4 Июня 2019
- 5005


